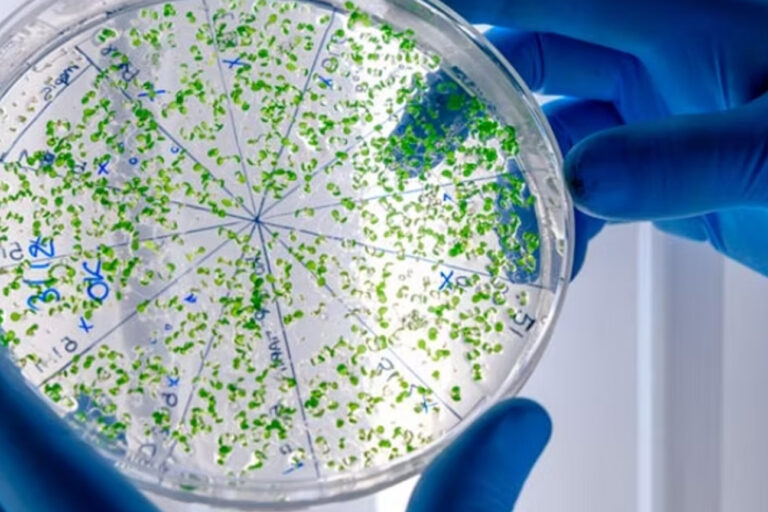

Ateneo organizado por la Comisión de Farmacovigilancia
Los antibióticos son los instrumentos más eficaces y disponibles para combatir una larga lista de bacterias que afectan la vida de los seres humanos, pero éstas, con el tiempo, han desarrollado la capacidad de resistir a la acción de estos medicamentos. El tema fue abordado en el último Ateneo, organizado por la Comisión de Farmacovigilancia, con la participación de dos expertos (Alejandra Beresovsky).
Como parte de las acciones que se realizan para concientizar sobre la importancia del uso adecuado de antibióticos, el Consejo de Médicos, a través de la Red de Farmacovigilancia que funciona en el marco de la institución, llevó a cabo el Ateneo sobre Resistencia Antimicrobiana (RAM).
En la actividad, participaron el bioquímico y microbiólogo Mg. Juan Enrique Martínez y el Doctor Federico Romero, con la coordinación de la doctora Claudia Guerrero.
En primer lugar, expuso Martínez –jefe de Microbiología del Hospital Universitario de Maternidad y Neonatología, dependiente de la UNC, donde también forma parte del Comité de Farmacovigilancia y es jefe del Servicio de Microbiología del Laboratorio Biocon–, quien destacó el desafío permanente que plantean a la humanidad la existencia de los microorganismos y cómo la resistencia antimicrobiana es un problema que nos atañe a todos como sociedad.
Martínez recordó que los antibióticos son los instrumentos más eficaces y disponibles para combatir una larga lista de bacterias que afectan la vida de los seres humanos, pero que éstas, con el tiempo, han desarrollado la capacidad de resistir a la acción de estos medicamentos.
En ese sentido, destacó que, según información publicada por la revista científica The Lancet en 2019, la RAM causa 1,3 millones de muertes por año en el mundo, al tiempo que otras casi cinco millones están asociadas a esta condición. En tanto, de acuerdo con la Organización Mundial de la Salud (OMS), la RAM es una de las 10 principales amenazas frente a las que se encuentra la humanidad. Desde resultados de tratamientos oncológicos hasta los de intervenciones como una cirugía mayor podrían verse en peligro si el paciente se ve infectado por alguna cepa resistente a los antibióticos.
Antecedentes
La RAM representa uno de los rasgos de supervivencia más trascendentes desarrollados por las bacterias en su evolución. Como todo ser vivo, cuando un microorganismo se desarrolla, busca perpetuarse, pasar vida a la generación siguiente, lo que explica que ellos mismos hayan desarrollado sus propios antimicrobianos, que les han permitido generar resistencia. “Se han encontrado genes de resistencia de antibióticos en microorganismos que están en la profundidad de los océanos, en lugares donde nunca llegó ningún antibiótico”, afirmó Martínez. “Por lo tanto, la información ya está dentro del propio microorganismo. Han estado entrenados durante miles de millones de años de evolución para estar en contacto con estas sustancias que desde su punto de vista son sustancias tóxicas, que ellos quieren, de alguna manera, eliminar”, añadió.
La RAM puede ser natural o adquirida. La primera comienza a expresarse ante la presencia del antibiótico, mientras que la segunda se adquiere por intercambio de material genético entre distintos microorganismos a través de mecanismos como la conjugación, transducción y transformación, así como mutaciones en el propio ADN cromosómico.
La bacteria puede ser resistente porque tiene menos permeabilidad al antibiótico, porque lo expulsa, porque se producen modificaciones enzimáticas en el sitio blanco o sitio diana (el que contiene los receptores capaces de unirse al fármaco) o por inactivación del fármaco.
Para cada mecanismo de acción de un antibiótico existe uno o más mecanismos de resistencia.
Como se mencionó anteriormente, estos mecanismos de resistencia están desde el inicio mismo de las bacterias, porque ellas mismas, antes de que existieran los antibióticos, ya lo tenían codificado en su ADN o se lo transmitían entre ellas para poder defenderse de situaciones tóxicas en los nichos ecológicos donde tenían que desarrollarse y perpetuar su vida. “El conocimiento de estos mecanismos nos puede ofrecer alguna ventana o alguna ventaja para tratamientos futuros en los que podamos devolver a esa bacteria la sensibilidad que tenía”, afirmó Martínez. No hay antibiótico que no tenga correlacionado su mecanismo de resistencia.
Además, es preciso tener en cuenta que las bacterias no viven aisladas, sino que están en lugares que permiten el contacto con otras y donde cuentan, también, con cierta protección, por ejemplo, la mucosa intestinal, los biofilm o biopelícula. “Las bacterias que están dentro del biofilm están protegidas por esa capa proteica, lo cual impide más todavía la llegada de los antibióticos y de los anticuerpos”, señaló Martínez.
Cuando están en esas superficies, producen una expresión de proteínas que están en una actividad muy baja, aletargadas, pero protegidas en ese biofilm. Esa mera persistencia, en algún momento, puede revertirse y la bacteria puede volver a su fase agresiva y producir enfermedades. Asimismo, la coexistencia con otras bacterias en el mismo biofilm permite que se transmitan entre ellas el material genético que permite la resistencia.

En conclusión, dijo Martínez, la RAM es un resultado evolutivo inevitable. “Solo podemos gestionarla, conocerla, ver cómo las bacterias se relacionan entre ellas, ver cuáles son los posibles sitios target que podemos tener para mejorar el tratamiento de las infecciones producidas por esas bacterias”, afirmó.
Es preciso evitar situaciones que profundizan el problema, como la prescripción inadecuada de antibióticos; la automedicación, uso inadecuado y excesivo de antibióticos; los entornos hospitalarios deficientes, donde no se guardan las prácticas mínimas de seguridad, desde un simple lavado de manos hasta la esterilización de los materiales, y moderar el uso extensivo en la agricultura. “Por ejemplo, para aumentar la cantidad de carne, sea porcina, aviar o vacuna, se utilizan en la producción toneladas de antibióticos. En el intestino de cada uno de esos animales se produce el biofilm y se intercambia material genético, todo ello repercute en la salud humana”, puntualizó.
Por otra parte, destacó que actualmente hay disponibles pocos antibióticos nuevos y que generalmente los que surgen al mercado son variaciones de los antibióticos que ya se conocen. “La industria farmacéutica tampoco está investigando demasiada cantidad de nuevas moléculas. Sí hay una cantidad de investigaciones y destinadas a modelos moleculares que tienen que ver con nanotecnología, con inteligencia artificial, edición genética con probióticos”, concluyó.
Visión desde la medicina
El segundo expositor fue Federico Romero, quien es médico, especialista en infectología en el Sanatorio Allende, coordinador del Comité de PROA (Programa para la Optimización del uso de Antibióticos) y es vicepresidente de la Sociedad de Infectología de nuestra provincia.
Romero coincidió con Martínez en que la oferta de antibióticos para tratamientos es muy acotada. “Estamos en una era crítica, con pocas moléculas nuevas y mecanismos de resistencia que nos van ganando rápidamente”, alertó.
El especialista hizo hincapié en el concepto de “una salud”: “Todo tiene repercusión; la salud humana se vincula con factores ambientales y con la salud del ámbito animal o veterinario”. Por otra parte, señaló que hay determinantes socioculturales, como los movimientos poblacionales, algo que dejó en claro la pandemia de Covid-19, que aceleró la RAM. “En tres años, el problema avanzó como si hubiera pasado una década”, graficó.
Y anticipó: “Las proyecciones muestran que en 2050 podrían producirse a nivel mundial 1,91 millones de muertes atribuibles y 8,22 millones de muertes asociadas a la RAM. Sur de Asia, América latina y el Caribe serán las regiones con la tasa más alta. El grupo etario más afectado será el de los mayores de 70 años”. Añadió, asimismo, entre los grupos más comprometidos, a las personas inmunodeprimidas.
Informó que el Centro para el Control y la Prevención de Enfermedades (CDC, por sus siglas en inglés) –cuya sede está en Atlanta y es la principal agencia federal de salud pública en Estados Unidos– destaca que existe, en muchos casos, una indicación errónea de antimicrobianos. Una revisión dada a conocer por la institución menciona que el 79% de los pacientes con neumonía habían recibido la indicación de tratamiento con antibióticos que no eran acordes a su cuadro o que no precisaban y que igual situación se presentó en el 77% de las personas con infecciones urinarias. Por otro lado, el 50% de las fluoroquinolonas –antibióticos bactericidas de amplio espectro– habían sido mal prescriptas y que, en un tercio de los casos, el uso de vancomicinas –que eliminan las bacterias en el intestino– había sido innecesaria.
En el caso de nuestro país, considera que existe “mucha libertad para el empleo de antibióticos de manera no supervisada, sobre todo en el ámbito ambulatorio”. Hizo alusión, asimismo, a los incentivos de los pacientes para pedirlos, como falsas creencias sobre su uso en distintos tipos de cuadros o incluso su precio relativamente bajo.
Por otra parte, algunos médicos terminan considerando, erróneamente, que es mejor administrar un antibiótico innecesario que evitar su uso en un paciente que podría beneficiarse. Es decir, piensan que la falta de prescripción pone en riesgo el bienestar del paciente, en un contexto de incertidumbre clínica.




